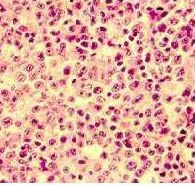
linfoma_nao_hodgkin_2_NET_OK.jpg

GADOLIN: benefício em linfoma não-Hodgkin
O estudo de fase III GADOLIN apresentou resultados positivos do anticorpo monoclonal obinutuzumabe no tratamento de pacientes com linfoma não-Hodgkin que progrediram ou se tornaram resistentes à terapia com rituximabe.
O estudo de fase III GADOLIN apresentou resultados positivos do anticorpo monoclonal obinutuzumabe no tratamento de pacientes com linfoma não-Hodgkin que progrediram ou se tornaram resistentes à terapia com rituximabe.



 Para celebrar seu 50º aniversário, comemorado em 2014, a Sociedade Americana de Oncologia Clínica (ASCO) solicitou à comunidade oncológica a indicação dos cinco avanços fundamentais na pesquisa do câncer e na assistência ao paciente ao longo dos últimos 50 anos.
Para celebrar seu 50º aniversário, comemorado em 2014, a Sociedade Americana de Oncologia Clínica (ASCO) solicitou à comunidade oncológica a indicação dos cinco avanços fundamentais na pesquisa do câncer e na assistência ao paciente ao longo dos últimos 50 anos.  Pacientes com câncer retal localmente avançado que receberam radioterapia pré-operatória com irinotecano mais capecitabina ou oxaliplatina e capecitabina têm uma taxa de sobrevida global em quatro anos de 85% e 75%, respectivamente.
Pacientes com câncer retal localmente avançado que receberam radioterapia pré-operatória com irinotecano mais capecitabina ou oxaliplatina e capecitabina têm uma taxa de sobrevida global em quatro anos de 85% e 75%, respectivamente.  A American Society for Radiation Oncology (ASTRO) apresentou os dados de longo prazo do estudo alemão ARO 96-02, com a análise de 10 anos de seguimento. O radio-oncologista Robson Ferrigno (foto), ex-presidente da Sociedade Brasileira de Radioterapia, analisa os resultados com exclusividade para Onconews.
A American Society for Radiation Oncology (ASTRO) apresentou os dados de longo prazo do estudo alemão ARO 96-02, com a análise de 10 anos de seguimento. O radio-oncologista Robson Ferrigno (foto), ex-presidente da Sociedade Brasileira de Radioterapia, analisa os resultados com exclusividade para Onconews. O especialista Ricardo Caponero (foto), oncologista clínico e ex-presidente da Sociedade Brasileira de Cuidados Paliativos, analisa estudo publicado no ‘The Journal of the American Medical Association’ (JAMA) e alerta para os desvios de conceber os cuidados paliativos como forma de economia na saúde.
O especialista Ricardo Caponero (foto), oncologista clínico e ex-presidente da Sociedade Brasileira de Cuidados Paliativos, analisa estudo publicado no ‘The Journal of the American Medical Association’ (JAMA) e alerta para os desvios de conceber os cuidados paliativos como forma de economia na saúde. O estudo COMBI-d anunciou no dia 6 de fevereiro os resultados finais de sobrevida global (SG) em pacientes de melanoma metastático com mutação BRAF V600E/K tratados com a combinação de dabrafenibe e trametinibe.
O estudo COMBI-d anunciou no dia 6 de fevereiro os resultados finais de sobrevida global (SG) em pacientes de melanoma metastático com mutação BRAF V600E/K tratados com a combinação de dabrafenibe e trametinibe.  Dois estudos publicados no periódico Cancer Gene Therapy (Volume 22, edição 1, Janeiro de 2015) apontaram o potencial de novas estratégias de tratamento para o glioblastoma, o tumor maligno mais comum do sistema nervoso central. Marcos Maldaun (foto), presidente da Sociedade Latino-Americana de Neuro-Oncologia (SNOLA), comentou os estudos com exclusividade para o Onconews.
Dois estudos publicados no periódico Cancer Gene Therapy (Volume 22, edição 1, Janeiro de 2015) apontaram o potencial de novas estratégias de tratamento para o glioblastoma, o tumor maligno mais comum do sistema nervoso central. Marcos Maldaun (foto), presidente da Sociedade Latino-Americana de Neuro-Oncologia (SNOLA), comentou os estudos com exclusividade para o Onconews.  A mídia internacional repercutiu as críticas ao estudo do Johns Hopkins publicado recentemente na revista Science. A pesquisa despertou polêmica ao atribuir ao azar dois terços das mutações associadas ao câncer, superando os fatores ambientais e genéticos combinados. No Dia Mundial do Câncer, o oncologista Evanius Wiermann, presidente da Sociedade Brasileira de Oncologia Clínica (SBOC), comenta a pesquisa e deixa um recado à comunidade médica brasileira.
A mídia internacional repercutiu as críticas ao estudo do Johns Hopkins publicado recentemente na revista Science. A pesquisa despertou polêmica ao atribuir ao azar dois terços das mutações associadas ao câncer, superando os fatores ambientais e genéticos combinados. No Dia Mundial do Câncer, o oncologista Evanius Wiermann, presidente da Sociedade Brasileira de Oncologia Clínica (SBOC), comenta a pesquisa e deixa um recado à comunidade médica brasileira. Artigo publicado no Lancet Oncology (Vol. 16 Number 1 | Jan 2015), assinado por Xavier Thomas, do Lyon-Sud Hospital, analisou a eficácia do blinatumomabe no tratamento de adultos com leucemia linfoblástica aguda.
Artigo publicado no Lancet Oncology (Vol. 16 Number 1 | Jan 2015), assinado por Xavier Thomas, do Lyon-Sud Hospital, analisou a eficácia do blinatumomabe no tratamento de adultos com leucemia linfoblástica aguda. A Nature publicou na edição online de 28 de janeiro estudo que demonstra o papel de enzimas epigenéticas em um subgrupo de pacientes com câncer de pulmão não pequenas células.
A Nature publicou na edição online de 28 de janeiro estudo que demonstra o papel de enzimas epigenéticas em um subgrupo de pacientes com câncer de pulmão não pequenas células.  Em artigo publicado no Lancet Oncology (Vol. 16 Number 1 | Jan 2015), Melina Arnold e colegas utilizaram o conhecimento disponível sobre a associação entre o índice de massa corpórea (IMC) e a incidência de câncer para estimar essa relação em diferentes países do mundo.
Em artigo publicado no Lancet Oncology (Vol. 16 Number 1 | Jan 2015), Melina Arnold e colegas utilizaram o conhecimento disponível sobre a associação entre o índice de massa corpórea (IMC) e a incidência de câncer para estimar essa relação em diferentes países do mundo. Estudo publicado no
Estudo publicado no  A nova tecnologia de fusão que combina imagens de ressonância magnética com ultrassom é mais eficaz do que a biópsia padrão na detecção de câncer de próstata de alto risco, de acordo com um estudo publicado no JAMA no dia 27 de janeiro. Mais de mil homens participaram da pesquisa, durante um período de sete anos.
A nova tecnologia de fusão que combina imagens de ressonância magnética com ultrassom é mais eficaz do que a biópsia padrão na detecção de câncer de próstata de alto risco, de acordo com um estudo publicado no JAMA no dia 27 de janeiro. Mais de mil homens participaram da pesquisa, durante um período de sete anos. A oncohematologista Vânia Hungria, do Grupo Brasileiro de Mieloma Múltiplo (GEBRAM), comentou com exclusividade para o Onconews os resultados finais do estudo ASPIRE, que confirmou o benefício da combinação de carfilzomibe, lenalidomida e dexametasona em pacientes de mieloma múltiplo refratários ou resistentes a outras linhas de tratamento.
A oncohematologista Vânia Hungria, do Grupo Brasileiro de Mieloma Múltiplo (GEBRAM), comentou com exclusividade para o Onconews os resultados finais do estudo ASPIRE, que confirmou o benefício da combinação de carfilzomibe, lenalidomida e dexametasona em pacientes de mieloma múltiplo refratários ou resistentes a outras linhas de tratamento.  Artigo publicado na edição online de 15 de janeiro do Lancet Oncology apresenta os dados finais do estudo que avaliou o acetato de abiraterona mais prednisona em pacientes com câncer de próstata metastático resistente à castração sem quimioterapia anterior (COU-AA-302).
Artigo publicado na edição online de 15 de janeiro do Lancet Oncology apresenta os dados finais do estudo que avaliou o acetato de abiraterona mais prednisona em pacientes com câncer de próstata metastático resistente à castração sem quimioterapia anterior (COU-AA-302).  O câncer de pâncreas ainda é pouco compreendido e as taxas de sobrevida em 5 anos têm ser mantido em cerca de 5% durante as últimas quatro décadas. Agora, uma nova técnica deve impulsionar a investigação sobre a doença ao ajudar a identificar as causas do câncer pelo sequenciamento genético e revelar grandes conjuntos de genes associados ao câncer de pâncreas. O estudo foi publicado na dição de dezembro da NatureGenetics.
O câncer de pâncreas ainda é pouco compreendido e as taxas de sobrevida em 5 anos têm ser mantido em cerca de 5% durante as últimas quatro décadas. Agora, uma nova técnica deve impulsionar a investigação sobre a doença ao ajudar a identificar as causas do câncer pelo sequenciamento genético e revelar grandes conjuntos de genes associados ao câncer de pâncreas. O estudo foi publicado na dição de dezembro da NatureGenetics. Um dos desafios mais importantes na oncologia hoje é o co-desenvolvimento de drogas-alvo capazes de atuar de forma sinérgica ou complementar, uma vez que as terapias baseadas em agente único têm levado geralmente a resultados modestos, apesar dos notáveis progressos alcançados. A análise é do British Journal of Cancer, em editorial que destaca a importância de novos esquemas no tratamento do câncer.
Um dos desafios mais importantes na oncologia hoje é o co-desenvolvimento de drogas-alvo capazes de atuar de forma sinérgica ou complementar, uma vez que as terapias baseadas em agente único têm levado geralmente a resultados modestos, apesar dos notáveis progressos alcançados. A análise é do British Journal of Cancer, em editorial que destaca a importância de novos esquemas no tratamento do câncer. 
